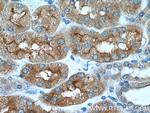
AQP7 Antibody in Immunohistochemistry (Paraffin) (IHC (P))

Search
Proteintech
AQP7 Polyclonal Antibody
{{$productOrderCtrl.translations['antibody.pdp.commerceCard.promotion.promotions']}}
{{$productOrderCtrl.translations['antibody.pdp.commerceCard.promotion.viewpromo']}}
{{$productOrderCtrl.translations['antibody.pdp.commerceCard.promotion.promocode']}}: {{promo.promoCode}} {{promo.promoTitle}} {{promo.promoDescription}}. {{$productOrderCtrl.translations['antibody.pdp.commerceCard.promotion.learnmore']}}
产品信息
25131-1-AP
种属反应
宿主/亚型
分类
类型
抗原
偶联物
形式
浓度
规格
纯化类型
保存液
内含物
保存条件
运输条件
产品详细信息
Immunogen sequence: LAAATIYSL FYTAILHFSG GQLMVTGPVA TAGIFATYLP DHMTLWRGFL NEAWLT (68-122 aa encoded by BC062701)
靶标信息
Aquaporins/major intrinsic protein (MIP) are a family of water-selective membrane channels. Aquaporin 7 has greater sequence similarity with AQP3 and AQP9 and they may be a subfamily. Aquaporin 7 and AQP3 are at the same chromosomal location suggesting that 9p13 may be a site of an aquaporin cluster. Aquaporin 7 facilitates water, glycerol and urea transport. It may play an important role in sperm function.
仅用于科研。不用于诊断过程。未经明确授权不得转售。
生物信息学
蛋白别名: AQP-7; AQPap; Aquaglyceroporin-7; Aquaporin adipose; Aquaporin-7; Aquaporin-7-like; MGC149555; MGC149556; RP11-311H10.6; unnamed protein product
基因别名: AQP7; AQP7L; AQP9; AQPap; GLYCQTL
UniProt ID: (Human) O14520, (Mouse) O54794
Entrez Gene ID: (Human) 364, (Mouse) 11832